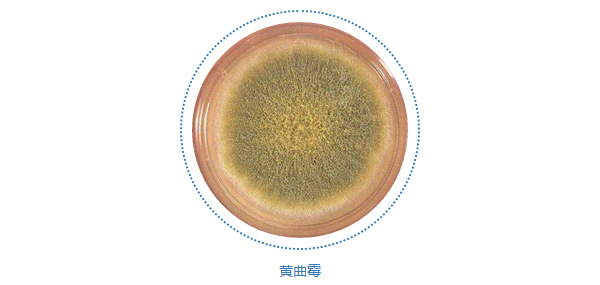
安化茯砖为啥有的金花少呢,黑茶金花茯砖里的黄点是霉点吗

现在,人们大多知道茯砖的好,是其内里的金花(学名“冠突散囊菌”)起了很大作用。
其实金花本身是没有营养的,它的作用是产生一种酶来帮助茶叶中的蛋白质,淀粉,多酚类物质的转化成对人体有益的物质。
茯砖茶中金花越多,品质上表现为:汤色更明艳亮润,口感更加甜滑甘爽,能加速消除粗青味和发酵中产生的堆味,且对消化系统及睡眠有所改善。
金花的生成,需要制成的茶品在外冷内热、外干内湿的前提下,茶叶较粗老且茶叶渗出物浓稠,且得有“冠突散囊菌”存在于茶原料内。
但是黄曲霉,也可能滋生在“湿仓”情况下,外观也呈黄色,却是众所周知的有害微生物。它生存在潮湿温热的环境中,依存于茶叶的营养而生长,生命周期结束后又靠孢子存留和繁殖。
那么要怎样区分有害的黄曲霉和有益的金花呢?
首先是长有黄曲霉的茶本身霉变发粘,尤其霉菌群落最密集处,茶叶凝结成块,冲泡时不易散开,叶极易碎。而有金花的茶品,条索清晰自然,久存后茶品也易分拆,冲泡后叶底较完整,有一定弹性。
其次,黄曲霉造成霉变过后,又存储在干燥环境的茶,霉菌体干瘪,形状不规则,且呈褐色或黄绿色。而“冠突散囊菌”任何时段,都是金黄色饱满的圆形颗粒,只有前后生长期大小的差异。

而在休眠期,黄曲霉只有黄色粉状孢子,但在生长期一定有菌丝形成,金花任何时期都决不会有菌丝存在。
还有,黄曲霉是丝状成片分布,为浅黄色,通常分布在茶品角部。金花通常在茶砖或坨、饼的内部,为点状颗粒,呈金黄色,即便有颗粒分布在同处,也是颗粒清晰。
此外,黄曲霉的孢子颗粒极细微且附着不紧,可以轻松吹散落,金花附着紧实,不易掉落。

冲泡后二者的区别更是明显,黄曲霉造成的霉变茶,汤色碳黑或棕黑,浑浊粘腻,味道有极强的霉变呛人气味,数泡后汤色很快变淡且依然浑浊。而有金花的茶,茶色偏橙或红,且较普通茶品更加明艳透亮,口感圆顺爽滑,有独特的菌花香,耐泡度亦较好。
掌握好这些要领,相信茶友们也能轻松地分辨,茯砖上的到底是“霉”还是“花”了。茶叶旦还是希望,茶友们得到的都是有金花的好茶。

本文通过说茶网转载。关注爱说茶公号:aishuocha(长按复制)茶叶的一切,你都能在这里知道。点击右下角【订阅】免费获取更多茶叶知识和信息。
【往期精选文章推荐】
《实验:茶汤属于酸性还是碱性?》
《这么喝茶,等于慢性自杀!(肠胃病患者应该这样喝茶)》
《详解:安吉白茶的冲泡方法》
《如何选购普洱茶:实例揭露普洱茶六大陷阱》